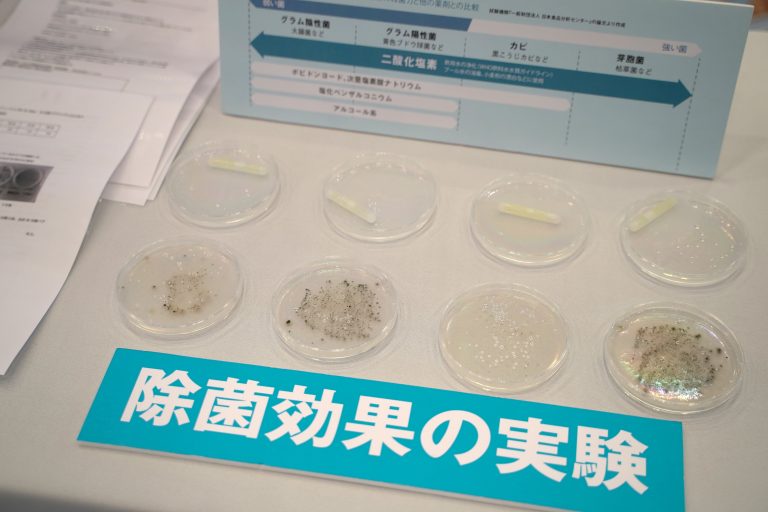

News
キャンペーン/イベント情報

「第4回 医療と介護の総合展 東京」出展レポート
株式会社ルミカは2021年10月13日(水)~15日(金)に幕張メッセで開催された「第4回 医療と介護の総合展 東京」(通称:メディカルジャパン東京)に出展いたしました。
多くのお客様に弊社ブースにお立ち寄りいただきました。
この場を借りて御礼申し上げます。
強い酸化力を持ち、除菌・消臭・ウイルス除去で大活躍する「二酸化塩素香」シリーズ。



お部屋空間向けのスプレータイプ
「二酸化塩素香POWER SPRAY-W」
反応させたスティックを水に浸けて、使いたいシーンに合わせた適度な濃度の二酸化塩素水を作ることができる
「二酸化塩素香POWER MIST-50」
ブレスレットタイプで気軽に身につけることができる
「二酸化塩素香POWER BRACE」
手軽に持ち運び携帯できるフック付き
「二酸化塩素香 POWER 6inch」
用途に応じてご使用いただけます。
また、新商品の「純粋二酸化塩素水 POWER WATER100」は世界初の抽出加工方法で精製した高濃度純粋二酸化塩素水です。
用途に合わせて希釈するだけで、簡単に適度な濃度の二酸化塩素水を作ることができます。


開発中の「BUBCLO2」を、今回初披露しました。
純粋二酸化塩素水をバブリングし、純粋な二酸化塩素ガスを発生させ、短時間で部屋を隅々まで燻蒸する装置です。
ホテル、病院、介護施設など人の入れ替わりがある場所で大活躍いたします。
種類は「BUBCLO2 HOME」「BUBCLO2 PRO」の2種類がございます。


「BUBCLO2 HOME」はタイマーにより、燻蒸開始から約20分間で自動的に動作が停止します。
「BUBCLO2 PRO」は「CLO2 SENSOR」というセンサーと接続することでセンサーからのWi-Fiを介して室内を設定した二酸化塩素濃度になるよう、自動で稼働を制御します。
また1台の「CLO2 SENSOR」で「BUBCLO2 PRO」を4台まで制御でき、より広い空間の燻蒸が可能となります。


「CLO2 SENSOR」からのWi-Fiに、タブレットを接続することで手元で本体の操作・濃度の確認ができます。
多目的ドームハウス「iPao(アイパオ)」シリーズからCAMPAO2型を施設と見立て、燻蒸の様子を実演しました。


「除菌効果の実験」ではカビや菌を培養した2種類の培地を用意。片方に二酸化塩素香 POWER 2inchスティックを入れておきます。
約1週間後、スティックを入れていない培地はカビが繁殖していますが、入れた培地はきれいな状態を保っています。
今回もイメージキャラクターの「クロラン丸(苦労蘭丸)」が二酸化塩素香製品を武器にしてブースに登場しました!


「二酸化塩素香 POWER 6inch」「二酸化塩素香POWER MIST-50」
「二酸化塩素香POWER SPRAY-W」「二酸化塩素香POWER BRACE」
「純粋二酸化塩素水 POWER WATER100」は
弊社運営のオンラインストア『ルミカの防災ストア』でお買い求めいただけます。
「iPao(アイパオ)」は弊社運営のオンラインストア『iPao Store』でお買い求めいただけます。
商品についてのご質問などございましたら、お気軽にお問い合わせ下さいませ。
お問い合わせはこちら
